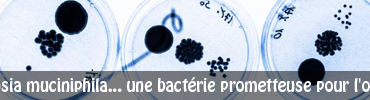

Développer son bon sens c’est faire preuve de réflexion. C’est aussi utiliser son intelligence pour donner du sens à sa vie, à celle de ses enfants, de sa famille… Dans une nouvelle étude publiée dans la revue International Journal of Obesity (1), les chercheurs nous expliquent qu’une routine réfléchie, au…
Une équipe de chercheur a examiné précisément les causes de mortalités liés à des comportement…
12% de la population est concernée par les migraines. La revue scientifique Neurology vient de…
L’exposition aux antibiotiques avant l’âge de 6 mois a été associée à un risque accru…
Nous savons que le surpoids porte préjudice à l’état de santé, la preuve en est.…
Les personnes en surpoids sont souvent accusées à tort. En effet, elles sont stigmatisées et…
Louis Pasteur aurait apprécié ce qui vient d’être révélé dans une récente étude publiée dans…
« Les antibiotiques c’est pas automatique », tout le monde connait aujourd’hui cette expression, et…
Pour baisser leur consommation de sucre, de nombreuses personnes favorisent les boissons light. Ces boissons,…
Plusieurs pathologies liées à la grossesse peuvent survenir lorsqu’une femme est enceinte. Tout d’abord le…